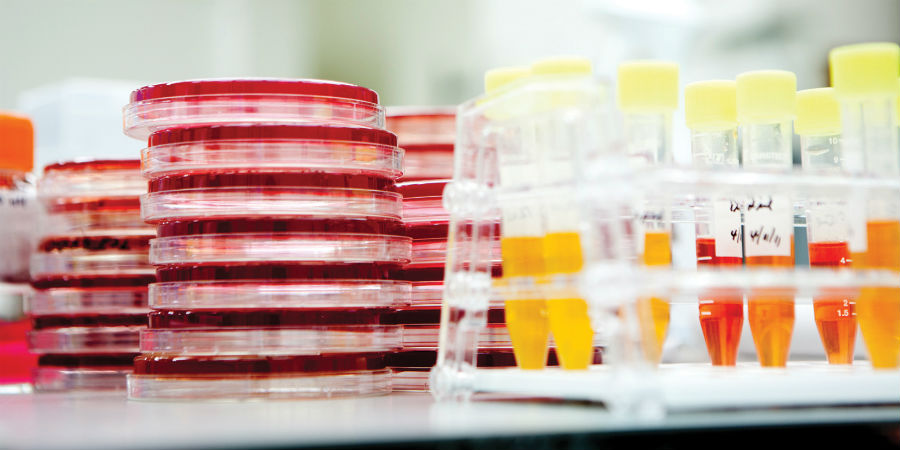

Amerikaanse wetenschappers creëren een bacterie met zo min mogelijk poespas. Zo’n minimalistisch organisme kan bruikbare stoffen voor ons maken. Ook leert de zoektocht ons meer over de minimale vereisten voor leven. Maar het bouwen blijkt moeilijker dan gedacht.
Het begon allemaal met de geboorte van Synthia in 2010. Synthia is geen persoon, maar een bacterie, een synthetische bacterie wel te verstaan. Het was de befaamde moleculair bioloog Craig Venter in dat jaar namelijk gelukt om met zijn team de bacterie Mycoplasma genitalium volledig te strippen van al haar DNA.
Vervolgens vulden de wetenschappers de cel met kunstmatig DNA: een licht aangepaste kopie van het oorspronkelijke DNA. De bacterie leefde en deelde zich vervolgens weer alsof er niks aan de hand was. Venter en collega’s hadden met de bestaande cel als basis, nieuw leven geschapen. En het was het eerste organisme op deze planeet dat geen voorouders heeft, behalve dan de computer.
Dit kunststukje was voor Venter echter pas het begin. Zoals hij destijds al aangaf, wilde hij zijn creatie uitkleden. M. genitalium is al een van de bacteriën met het minste aantal genen, maar het was de Amerikaanse pionier nog niet Spartaans genoeg. Hij is namelijk op zoek naar het kleinst mogelijke genoom, de minimale vereisten voor leven. M. genitalium en dus ook Synthia, hebben 525 genen: daar zitten er vast nog wel een paar bij die geen essentiële functie vervullen en dus overbodig zijn.
Hoeveel kun je er wegstrepen om toch nog een levende cel te behouden? En wat kun je daar vervolgens mee?
Deze vragen worden beantwoord in het artikel ‘minder genen, meer gesleutel’ te vinden in KIJK 6/2016. Dit nummer ligt in de winkel vanaf 26 mei tot en met 22 juni.
Meer informatie:
Tekst: Hidde Boersma
Beeld: Washington Post/Getty Images